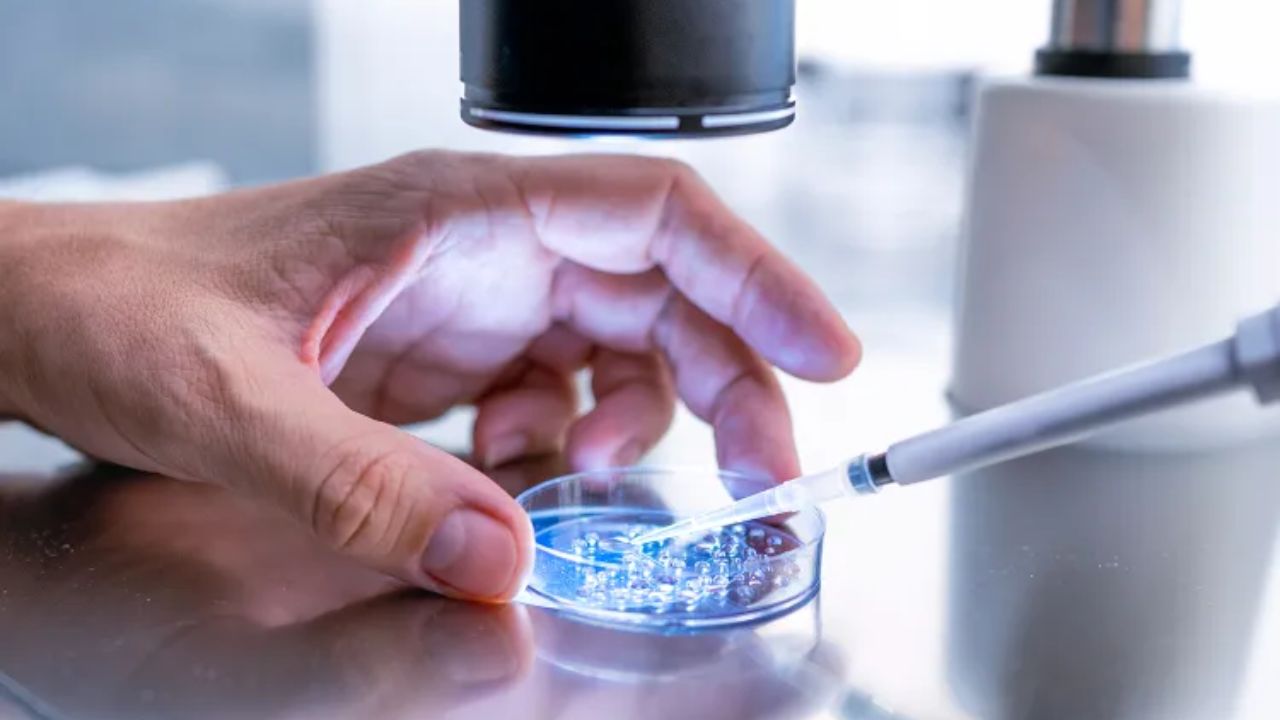
Oregon Woman Sues Fertility Clinic for $17 Million, Claiming Mother Was Inseminated With Wrong Man’s Sperm

Portland, Oregon — An Oregon woman has filed a $17 million lawsuit against two major health care providers, alleging that a fertility clinic mistakenly inseminated her mother with another man’s sperm — a mix-up that went undiscovered for more than four decades and permanently altered her family’s lives.
Court documents say the error occurred during fertility treatment in the early 1980s, but only came to light after modern genetic testing revealed the truth.
Lawsuit names major Oregon health systems
According to court filings obtained by PEOPLE, the plaintiff — identified as A.P., now 44 — is suing Oregon Health & Science University and Providence Health & Services of Oregon.
She is joined in the lawsuit by her biological mother, identified as C.W., and her father by marriage and upbringing, identified as K.W. Together, the family alleges the defendants committed a catastrophic error during fertility treatment that resulted in the wrong sperm being used for insemination.
The lawsuit seeks $17 million in damages for emotional distress, loss of familial bonds, and alleged concealment of the mistake.
Fertility treatment allegedly involved sperm mix-up
According to the complaint, C.W. and K.W. sought fertility care and family planning services after being referred by their physician. During the process, the lawsuit claims, the clinic mixed up K.W.’s sperm with that of another man, identified in court documents as R.W.
Instead of using K.W.’s genetic material, the clinic allegedly inseminated C.W. with R.W.’s sperm, resulting in a pregnancy neither parent consented to.
C.W. and K.W. welcomed their daughter, A.P., in December 1981, believing she was their biological child. At the same time, R.W. and his partner also became pregnant and welcomed a child of their own in November 1981, according to the lawsuit.
Truth uncovered decades later through DNA testing
For more than 40 years, A.P. was raised believing K.W. was her biological father. That belief changed two years ago, when she underwent genetic testing that raised immediate questions about her parentage.
According to the lawsuit, additional DNA testing confirmed that R.W. is her biological father, not the man who raised her.
The revelation, the family says, caused deep emotional trauma and upended their understanding of their family history.
Father says he was “stripped entirely” of biological parenthood
In the lawsuit, K.W. claims he was “stripped entirely” of his biological fatherhood of his firstborn child and that the loss continues to affect him every day.
The filing states that he is permanently reminded of what the family describes as a profound violation committed by the fertility clinic, one that cannot be undone regardless of the passage of time.
Mother describes invasion of bodily autonomy
C.W. also describes lasting emotional and physical harm stemming from the alleged mistake. According to the complaint, she says she was deprived of the experience of creating a child genetically connected to both herself and her husband.
The lawsuit states that she was forced to “bear the humiliation, discomfort, and physical distress” of carrying a pregnancy created using another man’s semen without her knowledge or consent.
C.W. characterizes the experience as a “severe invasion of her personhood”, arguing that her bodily autonomy and reproductive choices were violated.
Daughter calls herself a “product of nonconsensual birth”
Perhaps the most striking claim comes from A.P. herself. The lawsuit states that she is the “product of nonconsensual birth”, arguing that her existence was shaped by a medical error that stripped her parents of informed consent.
According to the filing, A.P. will endure lifelong doubt, frustration, and confusion about her identity and family relationships as a result of the alleged mistake.
The lawsuit also claims the defendants knew about the error and concealed the use of R.W.’s genetic material, refusing to acknowledge wrongdoing even after the truth emerged.
Read Also: Man and Three Dogs Found Dead Inside Philadelphia Home, Investigation Underway
Allegations raise broader concerns about fertility oversight
Cases involving fertility clinic errors have drawn increasing attention nationwide, prompting calls for stricter oversight, record-keeping standards, and transparency in reproductive medicine.
The plaintiffs argue that this case highlights how devastating such mistakes can be — not just medically, but emotionally and psychologically — when families discover decades later that foundational truths about their identities were wrong.
Neither OHSU nor Providence Health & Services of Oregon has publicly commented on the lawsuit as of the latest filings.
Legal battle just beginning
The case remains in its early stages, and the defendants have not yet filed formal responses to the allegations. The family says no amount of money can undo the harm, but hopes the lawsuit will bring accountability and prevent similar incidents in the future.
What’s your take on this case?
Should fertility clinics face stricter regulations and disclosure requirements? Share your thoughts in the comments and join the discussion with other readers following this developing legal battle.